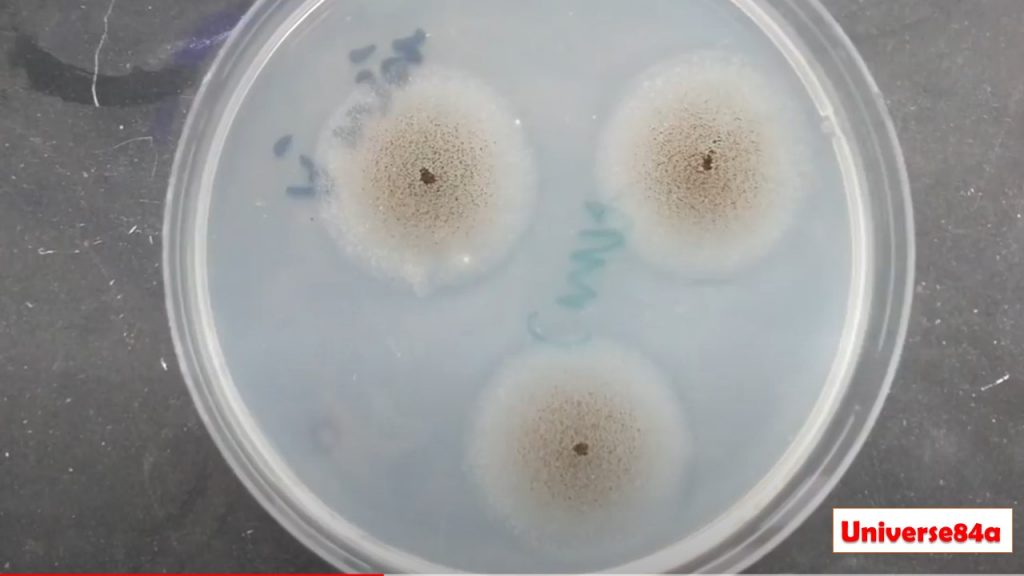
CMA: Introduction, Principle, Composition, Test Procedure, Colony Characteristics and Uses

CMA: Introduction, Principle, Composition, Test Procedure, Colony Characteristics and Uses
Introduction of CMA
CMA stands for Corn Meal Agar and it is a well-established fungal medium that is a suitable substrate for chlamydospore production by Candida albicans and the maintenance of fungal stock cultures. This is a very simple formulation containing only cornmeal infusion and agar. The addition of glucose (0.2 g% w/v) to CMA will enhance the chromogenesis of some species of Trichophyton e.g. Trichophyton rubrum. Corn meal agar is an enrichment medium developed by Hazen and Reed for use in the cultivation of fungi. Walker and Huppert, in 1960, found that the addition of Tween 80 to CMA resulted in rapid and abundant chlamydospore formation.
Principle of CMA
The medium consists of only cornmeal infusion and agar which is a very simple formulation. However, this infusion has enough nutrients to enhance the growth of fungi. Agar acts as a solidifying agent that provides a solid physical form. Cornmeal agar with tween 80, tween 80, a mixture of oleic esters, stimulates the production of chlamydospores by C. albicans, C. stellatoidea, and occasionally C. tropicalis and is also useful for the maintenance of fungal stock cultures.
Composition of CMA
(Hardy Diagnostics)
Corn Meal Agar (CMA) ingredients and their amounts are as follows-
Ingredients Gms / Litre
- Corn Meal Infusion: 2.0gm
- Tween 80: 7.0ml
- Agar: 15.0
- Distilled water(D/W): 1000 ml
- Final pH 6.2 +/- 0.3 at 25ºC.
Preparation of CMA
- Suspend 17.0 grams of Corn Meal Agar (CMA) in 1 liter purified/distilled or deionized water.
- Heat to boiling to dissolve the medium completely.
- Add 7 ml Tween 80.
- Sterilize by autoclaving at 15 lbs pressure (121°C) for 15 minutes.
- After autoclaving, leave for cooling to 45-50°C.
- Mix well before dispensing.
- Pour Corn Meal Agar into each plate and leave plates on the sterile surface until the agar has solidified.
- Store the plates in a refrigerator at 2-8°C.
Storage and Shelf life of CMA
- Store at 2-8ºC and away from direct light.
- Media should not be used if there are any signs of deterioration (shrinking, cracking, or discoloration), contamination.
- The product is light and temperature-sensitive; protects from light, excessive heat, moisture, and freezing.
Test Requirements
- Test specimens ( samples or fungal growth)
- Inoculating loop
- Bunsen burner
- Incubator
- Control strains (Candida albicans ATCC 10231 and Candida krusei ATCC 6258)
- Biological Safety Cabinet (BSC)
Test procedure
- Allow the plates to warm at 37°C or to room temperature, and the agar surface to dry before inoculating.
- Take plates.
- Using an inoculating needle, obtain visible paste of the organism. Draw the needle through the agar making two perpendicular lines in the shape of an “x”.
- Flame a coverslip and allow it to cool. Once the coverslip has cooled, place it over the central area of the “x” in order to reduce oxygen tension. Reduced oxygen tension stimulates chlamydospore production. Leave some growth uncovered.
- Seal the plate with tape or MycoSeals and incubate aerobically at room temperature (25-30ºC) for up to 72 hours in the dark. Examine daily for typical colonial growth and morphology.
- Invert the plate and examine microscopically using a low power objective (10 X). View along the edge of the coverslip for detection of chlamydospore formation.
- Follow steps one through six of the above procedure for the examination of sporulation of molds. Incubate until the mold is visible and mount coverslip in glycine.
- Examine microscopically for characteristic structures.
Result Interpretation of CMA
Using low power magnification, examine for the presence of budding cells, hyphae, blastospores, and chlamydospores. Most strains of C. albicans and C. stellatoidea form typical chlamydospores after 24-48 hours incubation. Examine daily for up to four days. C. dubliniensis will also form chlamydospores, but in clusters, rather than singles as with the C. albicans. Control strains, Candida albicans: Good growth; white colonies and chlamydospores while Candida krusei: Good growth; white / cream colonies, no chlamydospores.
Colony Characteristics of various organisms in CMA
Candida albicans: Growth; smooth white colonies after 24-48 hours
Trichophyton rubrum: Growth seen in 7 days and it may take 3-4 weeks for red color on the reverse side of the colony to be visible.
Uses of Corn Meal Agar (CMA)
- Corn Meal Agar (CMA) is a well-established fungal medium for chlamydospore production by Candida species.
- It is also useful for the cultivation of fungi.
- Corn meal agar is a nutritionally impoverished medium and thus it is useful for the maintenance of stock cultures of fungi, especially the black-pigmented varieties.
- The addition of glucose (0.2 g% w/v) to CMA is applicable for the chromogenesis of some species of Trichophyton e.g. Trichophyton rubrum.
Keynotes on CMA
- The addition of `Tween 80’ (e.g. 1%) to Corn Meal Agar greatly enhances the development of chlamydospores on the medium
- Mackenzie found that all 163 isolates of Candida albicans obtained from laboratories in the United Kingdom produced chlamydospores on Oxoid Corn Meal Agar but Dawson using only 27 isolates of Candida albicans, found that Oxoid Czapek Dox Agar and rice infusion agar were slightly superior for chlamydospore production
- A single Petri dish containing Corn Meal Agar may be used to identify four or five different colonies of Candida grown on Sabouraud Dextrose Agar. Using a straight wire, pick a colony off the surface of the latter medium and make a deep cut in the Corn Meal Agar (i.e. a horizontal furrow). Repeat for each colony. Place a flamed sterile coverslip over the line of inoculum. After incubation for 24 to 48 hours at 22°C, the streaks are examined microscopically, through the coverslip, using a low power objective. Along with such streaks, Candida albicans produces mycelium-bearing ball-like clusters of budding cells and the characteristic thick-walled round chlamydospores.
- Glucose supplemented Corn Meal Agar should not be used for chlamydospore production.
- Corn Meal Agar with `Tween 80’ (or other wetting agents) will allow Candida stellatoides and Candida tropicalis to produce chlamydospores.
- Some Candida strains lose their ability to produce chlamydospores after repeated subculturing.
Limitations of CMA
- Recommended temperature is 25ºC for the best results of Chlamydospore formation because of inhibition of Chlamydospore At 30-37ºC.
- Further tests need colonies from pure culture for complete identification like biochemical, immunological, molecular, or mass spectrometry
- A non-selective and selective medium should be inoculated for the isolation of fungi from potentially contaminated specimens.
- Repeated subculturing of some Candida strains result in a loss of their ability to produce chlamydospores.
Further Readings on CMA
- Medical Mycology. Editors: Emmons and Binford, 2nd ed 1970, Publisher Lea and Febiger, Philadelphia.
- Rippon’s JW: Medical Microbiology. The pathogenic fungi and the Pathogenic Actinomycetes. 3rd ed 1988 Publisher WB Saunder co, Philadelphia.
- Clinical Microbiology Procedure Handbook, Chief in editor H.D. Isenberg, Albert Einstein College of Medicine, New York, Publisher ASM (American Society for Microbiology), Washington DC.
- A Text-Book of Medical Mycology. Editor: Jagdish Chander. Publication Mehata, India.
- Practical Laboratory Mycology. Editors: Koneman E.W. and G.D. Roberts, 3rd ed 1985, Publisher Williams and Wilkins, Baltimore.
- http://himedialabs.com/TD/M146.pdf
- http://www.oxoid.com/UK/blue/prod_detail/prod_detail.asp
- https://catalog.hardydiagnostics.com/cp_prod/Content/hugo/CornMealAgarTween.htm
- https://www.sigmaaldrich.com/catalog/product/sial/42347
